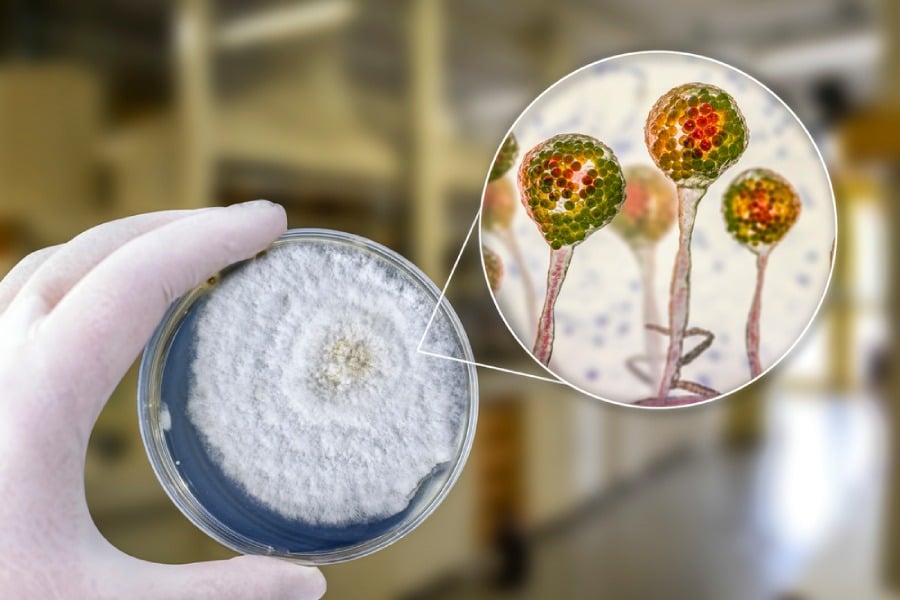
Тест за мукормикоза.

Мукормикоза – същност и лечение

Започваме с това, че мукормикозата не е заразна. Не се предава от човек на човек. Въпреки това може да я хванем от различни места в околната среда. Заболяването се развива най-често при хора с отслабена имунна система като пациенти с диабет, рак или такива на имуносупресивна терапия.
Инфекцията обикновено се предава чрез вдишване на спори и засяга основно синусите, белите дробове и мозъка, което изисква бърза диагноза и лечение за избягване на тежки усложнения.
Мукормикозата, известна още като черна гъбичка, е рядка, но опасна инфекция. Причинява се от група плесени, наречени мукормицети, и често засяга синусите, белите дробове, кожата и мозъка. Можем да вдишаме спорите на плесента или да влезем в контакт с тях от неща като почва, гниещи продукти, хляб или купчини компост.
Причини за поява на мукормикоза
Инфекцията може да се появи на всяка възраст при всеки човек. Повечето хора в някакъв момент от ежедневието си влизат в контакт с гъбичките. Вероятността да се разболеем е по-голяма, ако имаме отслабена имунна система поради лекарство, което приемаме, или поради:
- Диабет, особено когато не е под контрол
- ХИВ или СПИН
- Рак
- Трансплантация на органи
- Трансплантация на стволови клетки
- Неутропения (нисък брой неутрофили в кръвта – вид бели кръвни клетки)
- Дългосрочна употреба на стероиди
- Инжекционна употреба на наркотици
- Високи нива на желязо в тялото ви (хемохроматоза)
- Лошо здраве поради неправилно хранене
- Нездравословни нива на киселина в тялото (метаболитна ацидоза)
- Преждевременно раждане или ниско тегло при раждане
Също така има повишен риск от заразяване, ако е налично нараняване на кожата като изгаряне, порязване или рана. Докладвани са и случаи на мукормикоза при хора с COVID-19.
Макар и рядко, има хора, които са получавали мукормикоза в болници поради замърсено медицинско оборудване. Имало е и случаи на повече заразени след природни бедствия. Например силните торнада могат да разпространят голямо количество почва и да причинят разпространение на тези гъбички във въздуха.
Кои са най-честите симптоми?

Симптомите на мукормикоза зависят от това къде в тялото ни расте гъбичката. Те могат да включват:
- Треска
- Кашлица
- Болка в гърдите
- Недостиг на въздух
- Подуване от едната страна на лицето
- Главоболие
- Запушване на синусите
- Черни лезии по моста на носа или вътрешността на устата
- Болки в корема
- Гадене и повръщане
- Стомашно-чревно кървене
- Кръв в изпражненията
- Диария
Ако кожата ни е заразена, областта може да изглежда зачервена, подута или покрита с мехури. Също така е възможно да почернее или да я почувстваме по-топла или болезнена.
Инфекцията може да се разпространи и в други части на тялото чрез кръвта. Това се нарича дисеминирана мукормикоза. Когато това се случи, гъбичките могат да засегнат органи като далака и сърцето. В тежки случаи може да имаме промени с психическото си състояние или да изпаднем в кома. Най-лошото е, че мукормикозата може да бъде и смъртоносна.
Как се диагностицира и как се лекува?
Лекарите могат да обмислят варианта за наличие на мукормикоза въз основа на нашите симптоми и това дали имаме определени заболявания. Важно е да уведомим доктора си, ако сме били около развалени храни или други места, където често се откриват гъбични спори.
За да диагностицират мукормикоза, те насрочват снимки, за да получат изображения на засегнатите части от тялото ни и да тестват телесните ни тъкани за признаци на гъбички. Ако анализите сочат, че имаме белодробна или синусна инфекция, лекарят ни може да вземе проба от течността от носа или гърлото ни и да я изпрати за изследване в лаборатория.
Те могат също така да направят тъканна биопсия, като вземат малко парче заразена тъкан за изследване. Друг вариант е да се направят образни тестове като CT или MRI сканиране, за да се разбере дали инфекцията се е разпространила в мозъка или други органи.
Лечение
Ако сме диагностицирани с мукормикоза, трябва да се започне лечение възможно най-скоро с предписани противогъбични лекарства. Те могат да спрат растежа на гъбичките, унищожавайки ги и поставяйки инфекцията под контрол. Някои лекарства, които се изписват за лечение, могат да се приемат през вена (интравенозно) или с хапчета, които поглъщаме.
Лекарят може да започне с високи дози чрез интравенозно приложение, докато инфекцията бъде овладяна, което би могло да отнеме няколко седмици. След това е вероятно да преминем към хапчета.
Важно е да уведомим лекаря си, ако дадено лекарство има неприятни странични ефекти като стомашна болка или киселини.
Лекарите могат да променят плана ни за лечение. При проблеми с дишането трябва незабавно да се свържем с бърза помощ.
В тежки случаи може да се препоръча операция за отстраняване на заразена или мъртва тъкан, за да се предотврати разпространението на гъбичките. Това може да включва премахване на части от носа или очите. Може да бъде обезобразяващо, но е изключително важно тази животозастрашаваща инфекция да се лекува.
Как да избегнем мукормикоза?

Няма начин да избегнем изцяло вдишването на спори, но можем да направим няколко неща, за да намалим шансовете си за мукормикоза. Това е особено важно, ако имаме здравословен проблем, което повишава риска.
Един от съветите е да стоим далеч от места с много прах или пръст като строителни или изкопни обекти. Ако се налага да сме в тези зони, се препоръчва носене на маска. Друг важен ход е това да избягваме заразена вода. Това може да включва тази за пиене или дори наводнения и повредени от водата сгради особено след природни бедствия като урагани.
Ако имаме отслабена имунна система, може да се опитаме да избягваме дейности, които включват прах и почва, като градинарство или работа в двора. Ако няма как това да се случи, вариант е да се опитаме да предпазим кожата си с подходящи обувки, ръкавици, дълги панталони и ръкави. Ако имаме порязвания или ожулвания, добър съвет е измиването със сапун и вода възможно най-скоро.
Приемът на добавки или напитки за подсилване на имунитета или предотвратяване на гъбички също биха помогнали за превенция.
Заключение
Мукормикозата е опасна гъбична инфекция, която изисква навременна диагностика и незабавно лечение, особено при уязвими пациенти с по-слаба имунна система. Поради агресивния си характер заболяването може да доведе до сериозни увреждания на засегнатите тъкани и органи.
Затова профилактиката, редовният контрол на хроничните заболявания и избягването на потенциални източници на инфекция са от съществено значение. Повишената информираност за мукормикозата може да спаси живот и да предотврати тежки усложнения.
Често задавани въпроси
Какво представлява мукормикозата?
Мукормикозата е рядка, но тежка гъбична инфекция, причинена от плесени от рода Mucorales. Тя най-често засяга синусите, белите дробове и мозъка при хора с отслабен имунитет.
Кои хора са най-застрашени от мукормикоза?
Заболяването засяга предимно хора с отслабена имунна система, като пациенти с неконтролиран диабет, ракови заболявания, трансплантирани органи или такива на имуносупресивна терапия.
Как се предава мукормикозата?
Мукормикозата не е заразна. Инфекцията се предава чрез вдишване на гъбични спори от околната среда, а не чрез контакт между хора.
Блог
Рецепти
Популярни продукти
Свързани публикации
Сезонните заболявания са проблем, с който се борим непрекъснато. Прибавяйки напитки за повишаване на имунитета към ежедневната си
Много гъбички съществуват по повърхността и в човешкото тяло. Те се намират и навсякъде в околната среда –
Очни проблеми, като сухота в очите, поплавъци (мухи) и трептене на клепачите са често срещани и се свързват с фактори като стареене, стрес или напрежение.







